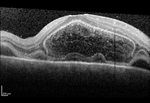

Spotlight Cases
Forty-Five With Fishtail Flecks
Thank you to James Berg, MD; Rishabh Date, MD; and Christina Y. Weng, MD, MBA.
A 45 year-old Caucasian male with no known ocular history presented with slowly progressive, painless bilateral vision over the past 6 years. He states that he has had poor color vision since childhood, but denies any flashes or floaters, trauma, or inciting event. Past medical history is significant only for well-controlled hypertension and hypercholesterolemia. Family history is notable for an older sibling also with poor bilateral vision; remaining family members including parents and children have normal vision.
Best-corrected visual acuity measured 20/60 OD and 20/50-1 OS with minimal myopic correction OU. His pupils, intraocular pressure, motility, and visual fields were within normal limits. Ishihara color plates were 4/17 OD and 3/17 OS. Anterior segment exam was notable for early nuclear sclerosis OU. Dilated funduscopic examination revealed bilateral yellow-white pisciform lesions located within the macula and throughout the periphery (Figure 1).
Spectral-domain optical coherence tomography (OCT) showed bilateral subfoveal atrophy with parafoveal ellipsoid layer irregularities (Figure 2). Fluorescein angiography demonstrated hyperfluorescence corresponding to the areas of the retina lesions along with a dark choroid (Figure 3).
What's Your Type?
Thank you to Walter T. Parker, MD and Christina Y. Weng, MD, MBA
A 63-year-old Indian female with no ophthalmic history presented with bilateral decreased vision for two years.
She reported no problems with glare or halos and denied a history of trauma. Her medical history included well-controlled diabetes mellitus and hypertension. Family history was negative for any ocular conditions.
Best-corrected visual acuity was 20/50 OD and 20/63 OS. Pupils, intraocular pressure, confrontational visual fields, and motility were normal in both eyes. Slit lamp examination revealed normal findings aside from bilateral 2+ nuclear sclerotic cataracts with trace cortical changes. Dilated funduscopic examination revealed retinal pigment epithelium mottling in the central macula with a slightly grayish sheen juxtafoveally and perifoveal telangiectatic vessels. Otherwise, the optic disc, vitreous, vessels, and periphery appeared normal (Figure 1).
Spectral-domain optical coherence tomography (OCT) demonstrated intraretinal hyporeflectivity and ellipsoid layer disruption with a preserved foveal contour in both eyes (Figure 2). Fundus autofluorescence (FAF) revealed hyperautofluorescence temporal to the fovea (Figure 3). Fluorescein angiography (FA) showed juxtafoveal hyperfluorescence with leakage (Figure 4).
Latest Case: 11 Years to Catch a Butterfly
Thank you to Jennifer Murdock, MD; James Berg, MD; and Christina Y. Weng, MD, MBA
A 39-year-old healthy female veteran initially presented with visual distortion in both eyes for a few months. She denied a history of trauma, pain, floaters, chemical or laser exposure, or photopsias. The patient reported no family history of ocular disease. Best-corrected visual acuity (BCVA) was 20/20 in both eyes. Pupils, motility, visual fields by confrontation, and intraocular pressure were normal. Slit lamp examination was unremarkable. Dilated funduscopic examination revealed multiple areas of hypopigmentation with interspersed RPE clumping in the central macula bilaterally (Figure 1). The peripheral retina demonstrated no abnormalities. Fluorescein angiography revealed multiple hypofluorescent lesions in the macula with encircling hyperfluorescence (Figure 2).
The patient was lost to follow-up and presented 11 years later when she was 50-years-old complaining of continued decline in vision. BCVA was 20/20 in both eyes with a minor myopic refractive error. Dilated fundus examination now showed a flat central area of hypopigmentation with irregular borders, which appeared larger than that in previous exams (Figure 3). A greater degree of RPE pigment clumping was seen within the lesion. The nerve, vessels, vitreous, and peripheral retina were within normal limits. OCT showed bilateral parafoveal irregularity at the level of the RPE (Figure 4). FA showed a larger confluent area of central hyperfluorescence with scattered hypofluorescence (Figure 5).
Peripapillary Puzzle
Shazia F. Ali, MD, and Christina Y. Weng, MD, MBA

A 64-year-old healthy female with a history of myopia and pigmentary glaucoma was referred by a glaucoma specialist for a “lesion” abutting the optic disc in the left eye. The patient was asymptomatic with no visual complaints. Best-corrected visual acuity (BCVA) in the right eye was 20/20 (MRx -1.75 + 0.25 x 020) and left eye was 20/25 (-5.75 + 0.75 x 056). Intraocular pressure (IOP) was normal on her two IOP-lowering drop regimen. There was no afferent pupillary defect. Slit lamp examination of the right eye was unremarkable aside from 1+ nuclear sclerosis; her left eye was notable for diffuse corneal endothelial pigment, iris transillumination defects, and a 1+ nuclear sclerosis.
Dilated funduscopic examination of the left eye showed a cream-colored lesion approximately 1 disc area in size located inferior to the disc (Lead Image); the macula, vessels, vitreous, and periphery were otherwise normal. No hemorrhage or fluid was visualized. Spectral-domain optical coherence tomography (OCT) of the nerve showed a choroidal hyporeflective space without subretinal fluid or overlying retinal pigment epithelium abnormality (Figure 1). Fluorescein angiography (FA) revealed early hypofluorescence in the area of the lesion with late staining and no leakage (Figure 2). A-scan/B-scan ultrasonography of the lesion demonstrated medium-high internal reflectivity without significant elevation (Figure 3). Fundus autofluorescence (FAF) revealed no significant abnormalities (Figure 4). The right fundus was unremarkable without similar findings.
Two Sparkling Retinas
Bryan M. Roth, MD, and Christina Y. Weng, MD, MBA

A 41-year-old Caucasian female presented with a 1-year history of glare in both eyes, worse at night. She denied any ocular history. Medical history was significant only for conductive hearing loss on the left with associated stapes replacement 3 years ago. She denied any medication use or illicit drug use. She works as a dance professor and denies any toxic exposure.
On examination, her best-corrected visual acuity was 20/20 in both eyes. The intraocular pressure and pupillary examinations were normal. Color vision was tested; she was able to distinguish 2/10 Ishihara plates in the right eye and 1/10 plates in the left eye.
Anterior examination was unremarkable with clear cornea and clear lens OU. Dilated fundus examination demonstrated numerous fine, white-yellow crystalline deposits in the posterior pole extending just beyond the arcades. Optic nerves appeared pink and sharp, and the vessels appeared normal. Optical coherence tomography revealed severe ellipsoid zone atrophy with foveal sparing. There were hyperreflective foci scattered throughout all retinal layers. Fundus autofluorescence demonstrated heterogeneous hypoautofluorescence of the posterior pole. ERG performed at an outside institution demonstrated a reduction in amplitudes of both photopic and scotopic responses.
You'll Shoot Your Eye Out, Kid!
William J. Carroll, MD, Philip W. Laird, MD, and Jiong Yan, MD

An 11-year-old boy was shot in the right eye with a Copperhead BB. He presented to the emergency room on the day of the injury and was found to have 20/200 visual acuity in the injured eye with a relative afferent pupillary defect. Intraocular pressure was 18, there was mild anterior chamber cell, a clear crystalline lens, inferior vitreous hemorrhage, a pink optic disc, globular vitreous hemorrhage over the posterior pole, Berlin’s edema, and a large area of inferonasal sclopetaria. B-scan ultrasonography showed a hyper-reflective foreign body adjacent to the sclera in the inferonasal orbit.
Computed tomography revealed a single metallic foreign body adjacent to the globe consistent with a BB. No evidence of a penetrating injury was noted. Removal of the foreign body was deferred by the oculoplastics service.
One month after the injury, visual acuity had improved to 20/100. Dilated fundus exam showed the findings in figure 1.
Runs in the Family
James P. Berg, MD, and Christina Y. Weng, MD, MBA

A 30-year-old male presented with a 6-week history of blurry vision OS. He was previously seen by an optometrist and another retinal specialist who both told the patient that he had a retinal detachment and referred him to our clinic. The patient states that he sees a “curtain” intermittently in the superior periphery of his left eye; his right eye is stable. His past ocular history is significant for bilateral scleral buckles (age 4) and multiple laser treatments in both eyes, and he reports having had chronically poor vision since early childhood. His family history is pertinent for a maternal grandfather and uncle with poor vision. He reports no history of trauma.
His best-corrected visual acuity was 20/100 OU with normal pupils and intraocular pressures. Visual fields tested grossly by confrontation did confirm a superior deficit in both eyes. Anterior examination was notable only for trace nuclear sclerotic cataracts OU. Dilated funduscopic examination of his right eye revealed a normal disc and vessels, macular schisis without hemorrhage, and a peripheral encircling buckle with dense inferotemporal laser. Left fundus showed similar findings, but also had an area of elevation inferotemporally without tears or holes that was encroaching upon the anterior border of laser scars.
Spectral-domain optical coherence tomography (OCT) revealed bilateral macular retinoschisis without subretinal fluid (Figure 1). OCT scan was also performed through the inferotemporal elevation and confirmed the presence of retinoschisis without retinal detachment (Figure 2). B- and A-scan ultrasound (images not shown) of the left eye’s inferotemporal quadrant revealed a thin, taut area of elevation with a corresponding narrow spike on A-scan consistent with retinoschisis.
Retinitis Pigmentosa...And The Some
James P. Berg, MD; Megan N. Scott, MD; and Christina Y. Weng, MD, MBA

The Great Masquerader
Oussama Boundaoui, MD and Heena Patel, MD

A 51-year-old Caucasian man with HIV, maintained on highly active antiretroviral therapy (HAART), was referred by an urgent care center for a possible detached retina in the left eye. He had presented to the urgent care clinic 1 week prior with acute blurred vision in the left eye along with floaters. He denied photopsia or ocular pain. His last CD4 count was 600, and viral load was undetectable. Medical and social history showed he was sexually active (MSM) and was otherwise unremarkable, and review of systems was negative.
On exam, his vision was 20/30 and 20/70 (unimproved with pinhole) in the right and left eyes, respectively. Pupils were both symmetrically reactive without afferent pupillary defect, and intraocular pressures were normal. Stellate keratic precipitates were noted in both eyes, but the anterior segment was otherwise quiet, without acute or chronic signs of inflammation. Posterior segment exam on the right eye showed moderate-to-severe disc edema. The left eye likewise showed moderate-to-severe disc edema with peripapillary flame-shaped hemorrhages and multiple small subretinal placoid pigmented lesions distributed within the arcades throughout the macula. The peripheral retina appeared attached, and no vitritis was seen.
SD-OCT of the right and left eyes showed disruption of the outer retinal segments and retinal pigment epithelium. Fluorescein angiography of both eyes revealed a characteristic “leopard pattern” of hypofluorescent placoid macular lesions in the early phase, with late phase hyperfluoresence.
The patient was sent to the emergency department urgently to obtain stat neuroimaging, lumbar fluid analysis, and a laboratory panel for suspected infectious etiology. Serum RPR testing for syphillis was reactive at 1:128, and confirmatory MHA-TP was likewise positive. The patient was promptly admitted to the inpatient ward to start a 14-day IV penicillin course for neurosyphilis.
Case of Mysterious Central Serous Chorioretinopathy
Alan Sheyman, MD; Fabio Scarinci, MD; and Lee Jampol, MD

Our patient, RT, is a 58-year-old man with a past ocular history of high myopia, who carries a diagnosis of chronic central serous chorioretinopathy (CSCR) in both eyes. He is being referred for further evaluation and has no relevant past medical history. RT presented 6 years ago with slowly declining vision in both eyes, the right worse than left. At that time, he was diagnosed with central serous chorioretinopathy (CSC) in the right eye and underwent photodynamic therapy.
Over the next several years, he developed CSC in the other eye as well. The patient underwent numerous treatment modalities, including full-fluence photodynamic therapy, half-fluence photodynamic therapy, intravitreal bevacizumab injections, intravitreal dexamethasone injections (for presumably a separate diagnosis then CSCR), acetazolamide , and topical brimonidine. However, subretinal macular fluid persisted in both eyes and the patient’s vision continued to deteriorate.
RT’s best corrected visual acuity is 20/125 in the right eye and 20/60 in the left eye. His refraction is -7.00 sphere in the right eye and -7.25 sphere in the left eye. His intraocular pressures are 14 and 16, respectively. His conjunctiva, cornea, anterior chamber, and iris exams are not remarkable. Both eyes have 1+ nuclear sclerotic cataracts.
A Sneaky Spot
Stephanie B. Engelhard, BA, and Ashvini K. Reddy, MD

A 68-year-old female with a 10-year history of bilateral chorioretinal scars presents for routine follow-up examination. She takes no local or systemic medications and denies any changes in vision, new floaters, or new visual field defects since her last examination 4 months prior. She has previously tested negative for tuberculosis. Visual acuity is 20/20 OD and 20/30 OS, and external examination, extra-ocular motility, and intraocular pressures are normal. She does have an afferent pupillary defect OS unchanged from previous examinations. Visual field testing is remarkable for an enlarged blind spot OD and a paracentral scotoma OS. Slit lamp examination reveals mild nuclear sclerosis without anterior chamber inflammation or vitritis. In the right eye, the patient has a new area of chorioretinal atrophy (figure 1B) compared to 4 months prior (figure 1A). This area is hyperautofluorescent (figure 2). The left eye has multiple, coalescent areas of atrophy (figure 3), all of which are hypoautofluorescent (figure 4).
A Matter of Names
Enchun M. Liu, MD, and Bradley T. Smith, MD
A 25-year-old Caucasian female with 1 week of photopsias in her left eye was referred to our office to rule out a retinal tear. The patient described the sudden onset of a blurry spot in her left eye and a sensation “like someone taking pictures with a camera flash.” Her past ocular history was unremarkable. She had a past medical history of migraines and seasonal allergies. Aside from birth control pills, she used no other medications except over the counter allergy medication, as needed. A review of systems was significant for a recent upper respiratory illness 3 weeks prior to presentation.

Her visual acuity was 20/20 in the right eye and 20/20-2 in the left eye. There was no relative afferent pupillary defect in either eye. Intraocular pressures by applanation were 13 and 15 in the right and left eyes, respectively. The anterior chambers were deep and quiet and there was no evidence of vitritis in either eye.
On dilated fundus examination, the optic nerves were sharp and pink in both eyes. The macula in the right eye was normal, but the left macula showed a subtle reddish-brown lesion nasal to the fovea (Figures 1a and 1b). The vessels and periphery were otherwise unremarkable in both eyes.
Spectral domain optical coherence tomography (SD-OCT) was obtained to better characterize the macular lesion in the left eye. The SD-OCT revealed a discrete hyperreflective band nasal to the fovea in the outer nuclear layer (Figure 2b). There was also disruption of the inner segment/outer segment junction (IS/OS, or ellipsoid zone) in addition to the OS/RPE junction (interdigitation zone) in this area. The corresponding infrared image (IR) of the SD-OCT showed a sharply demarcated wedge-shaped lesion along the papillomacular (PM) bundle pointing to the fovea (Figure 2a).
Presumed Ocular Histoplasmosis
Ashvini K. Reddy, MD, Younhee J. Choi, BS
A 58-year-old Caucasian male presented with a 2-week history of decreased vision with distortion OS. His medical history was significant for chorioretinal scars OU. He specifically denied any history of flashing lights, fevers, floaters, or pain.

External examination was within normal limits. Visual acuity was 20/25 OD and 20/200 OS. Pupillary responses, visual fields by finger confrontation, extraocular movements, and intraocular pressures were all normal. Slit lamp examination was remarkable for mild nuclear sclerotic cataracts OU with no anterior chamber cell or flare. The vitreous was clear OU. Fundus examination revealed peripapillary atrophy, OS worse than OD, with moderate cupping of the optic discs ( Figure 1). The macula OD was flat without cystoid macular edema. A large subretinal hemorrhage was present OS. The retinal vasculature was within normal limits OU. Cobblestone changes and punched-out chorioretinal scars were seen in the periphery OU.
Optical coherence tomography revealed fibrosis and edema OS. Fluorescein angiography was performed.
What Are You Doing There?
Benjamin J. Thomas, MD, Yoshihiro Yonekawa, MD, Lisa J. Faia, MD, Tarek S. Hassan, MD

A 26-year-old woman was referred to the clinic with complaints of acute floaters and flashes of light in her left eye (OS) without associated vision loss. She reported that her symptoms had begun spontaneously approximately 3 days prior to presentation and had been constant since then. She denied any recent ocular trauma, and review of systems was otherwise negative. Her past medical history was notable for only intermittent migraine headaches, for which she took acetaminophen as needed. Her past ocular history was unremarkable, and family and social histories were noncontributory. Her right eye (OD) remained asymptomatic.
On examination, her best-corrected visual acuity (BCVA) was 20/40 OD and 20/25 OS. Auto-refractor testing revealed only minimal hyperopia. Intraocular pressures (IOP) were within normal limits, but asymmetric at 12mmHg OD and 18mmHg OS. Pupillary examination was normal, as was anterior segment examination. Dilated fundus examination OD was unremarkable; however, posterior segment examination of the OS was notable for a localized serous retinal detachment (RD) in the nasal peripheral retina, approximately 1 disc-diameter (DD) from the optic nerve. The vitreous was clear, and the optic nerve demonstrated sharp margins, without edema or hemorrhage. The retinal vasculature and macula were, likewise, unremarkable. The retinal periphery was notable only for the dome-shaped serous RD, which was approximately 3- to 4-DD in diameter, well-circumscribed, with a faint “graying” of the outer retina surface. Peripheral retinal examination of both eyes with scleral depression was unremarkable.
Fluorescein angiography (FA) and optical coherence tomography (OCT) images were also obtained. FA OS showed hyperfluorescence consistent with pooling corresponding to the nasal serous RD, as well as adjacent hyperfluorescent staining. FA OD was unremarkable. Macular OCT OS revealed intact retinal layers and normal foveal contour; however, a scan of the nasal retina showed a well-circumscribed serous RD with associated thickening of the outer retinal layers and overlying vitritis. Again, imaging OD was within normal limits.
What is the Meaning of all This Fluid?
R. Rishi Gupta, MD, FRCSC, Sweta Tarigopula, MD, and John Chen MD, FRCSC
A 28-year-old, nonpregnant, mildly myopic, Caucasian female presented with a 4-day history of progressive worsening of visual acuity, sequentially in the left eye (OS), and then right eye (OD). Her past medical history and past ocular history were unremarkable, and she did not take any medications. A review of systems was negative.
On examination, best-corrected visual acuity (VA) was counting fingers OD and hand motion OS. Intraocular pressures, extraocular movements, and visual field testing by confrontation were normal, and there was no relative afferent pupillary defect. Slit lamp examination of the anterior segment revealed ½+ cell and ½+ flare in both eyes (OU), with no keratic precipitates and no vitreous cell observed. Dilated fundus examination showed mild disc hyperemia, but no obvious edema. The posterior pole of each eye had multiple circumscribed areas of subretinal fluid, with no evidence of hemorrhage or vasculitis.
Chloroquine
Ashvini K. Reddy, MD, and Jason Franklin, BA

An 81-yearold Caucasian woman with a history of rheumatoid arthritis is referred for chronically decreased vision. She took an unknown dose of chloroquine for 17 years and discontinued the medication 25 years prior to her visit. She currently takes leflunomide (Arava, Sanofi, Bridgewater, NJ) for rheumatoid arthritis.
Best-corrected visual acuity (BCVA) is 20/30 right eye and 20/20 left eye. Pupillary reaction is brisk in both eyes with no afferent pupil defect (APD). Extraocular muscles (EOM) and intraocular pressure (IOP) are within normal limits. Examination of external exam, lids, lashes, conjunctiva, and sclera are unremarkable. Corneas are clear without verticillata. The anterior chamber is deep and quiet, with no abnormalities of the iris noted. She is bilaterally pseudophakic, and the vitreous is clear. On fundus exam, the discs are healthy with well-defined margins and a cup-to-disc ratio of 0.4 in both eyes. Examination of the macula is remarkable for pigmentary changes in a ring distribution around the fovea. The vessels appear normal bilaterally. Peripheral pigmentary mottling is noted in both eyes.
Shaken Up
Siddharth Menon, MS, Christopher D. Weaver, MD, and Ashvini K. Reddy, MD
A 13-month-old boy with asthma and no ocular history was brought to the hospital after being found minimally responsive. Per history, the child was laid down for a nap on a futon at 10:30 a.m. that day. Around 11:30 a.m., the mother's boyfriend heard the patient fall from the futon where he was sleeping and found him unconscious with shallow breathing. At that time, an ambulance was called and arrived within eight to ten minutes of contact. Cardiopulmonary resuscitation was initiated. Air transport then transferred the patient to a tertiary care hospital. The patient was admitted, intubated, and underwent extensive full-body imaging. Pupils were noted to be minimally reactive. Ophthalmology was consulted.

A CT of the head showed an epidural hematoma and intraventricular hemorrhage in the lateral and third ventricles. On skeletal survey, no other fractures were identified. Ophthalmologic examination was remarkable for bilateral 4.5 mm pupils, which were nonreactive. There was no resistance to retropulsion. Tactile tensions were soft in both eyes. Portable slit-lamp examination at bedside was unremarkable. Dilated fundus examination was notable for discs obscured by hemorrhage bilaterally, with extensive preretinal, intraretinal, and subretinal hemorrhages without obvious macular retinoschisis.
The Not-So-Classic Caucasian Patient in a Retina Clinic
Natalia Vila, MD, Michael A. Kapusta, MD, and David E. Lederer, MD

A 57-year-old Caucasian woman presented with decreased visual acuity (VA) in the right eye for 1 month. Ocular history was remarkable for refractive amblyopia (+5D) in the left eye. She denied any ocular history (inflammatory disorders, trauma, family history of hereditary conditions), or medical history.
On examination, her best-corrected visual acuity (BCVA) was 20/100 OD and 20/400 OS. Intraocular pressures and anterior segment examination were within normal limits OU. Fundus examination demonstrated an extrafoveal subretinal nodular elevation with subretinal fluid (SRF) and lipid exudation. Fluorescein angiography (FA) revealed early hyperfluorescence and late leakage surrounding the lesion. Optical coherence tomography (OCT) revealed the presence of a pigment epithelial detachment (PED), cystoid thickening, and SRF.
Steroids Can Pump You Up!
Patrick Oellers, MD, Sharon Fekrat, MD, and Glenn Yiu, MD, PhD
A 39-year-old African American man with a history of sarcoidosis and renal transplantation was treated for acute retinal necrosis (ARN) syndrome in the right eye. Peripheral retinal whitening with perivascular sheathing was present in the right eye.

Polymerase chain reaction (PCR) of aqueous fluid confirmed the presence of herpes simplex virus (HSV). Treatment with intravitreal foscarnet x 3 and oral prednisone 60 mg daily followed by slow taper led to progressive resolution and consolidation of the retinal lesions. The left eye remained normal.
Three months after this episode, he presented with mildly decreased visual acuity (VA) in the right eye. At this time, he was using:
- Topical prednisolone acetate 1% every 2 hours
- Oral prednisone 10 mg daily (5 mg above baseline dosage for renal transplant rejection prophylaxis)
- Oral mycophenolate mofetil 500 mg BID
- Oral tacrolimus 8 mg BID
- Oral valacyclovir 1000 mg daily for antiviral prophylaxis
Examination revealed VA of 20/25 in the right eye. Slit lamp biomicroscopy showed rare residual pigmented keratic precipitates (KP) and trace posterior subcapsular cataract (PSC), but no anterior chamber or vitreous cells. Dilated ophthalmoscopy demonstrated foveal subretinal fluid (SRF) and scattered macular and peripheral chorioretinal scars without active retinitis in the right eye (Figure 1A).
The fundus exam of the left eye remained normal (Figure 1B). Optical coherence tomography (OCT) showed a small amount subfoveal fluid in the right eye and a compact fovea in the left eye (Figures 1C, 1D).
Ironing Out the Details
William Pearce, MD; Steven Yeh, MD; and Jiong Yan, MD
A 26-year-old Hispanic female was admitted to the hospital for complications of graft-vs-host disease after a bone marrow transplant for aplastic anemia. She had been hospitalized for a prolonged period and was receiving multiple intravenous (IV) infusions. On hospital day 87, she began to complain of photopsias and central scotomata in both eyes.

On examination, visual acuity was 20/200 in the right eye and 20/100 in the left eye. The intraocular pressure, pupillary and anterior segment examinations were normal. A dilated fundoscopic exam revealed clear vitreous and pink and sharp optic nerves. There was hypopigmentation of the peripapillary and perifoveal retinal pigment epithelium (RPE) with subfoveal vitelliform lesions in both eyes. The arterial vasculature was mildly attenuated, and the retinal periphery was normal in both eyes.
Optical coherence tomography (OCT) and fundus autofluorescence (FAF) were obtained. A fluorescein angiogram (FA) could not be performed due to lack of vascular access. The OCT demonstrated hyperreflective material in the subfoveal outer retina and a vitelliform detachment in both eyes. The FAF revealed a peripapillary and perifoveal speckled, hyperautofluorescent pattern. Goldmann visual fields confirmed a cecocentral scotoma in both eyes.
Further review of the medical record revealed that the patient had received IV infusions of at least 20 different medications, including: acyclovir, cyclosporine, deferoxamine, filgrastim, granisetron, methylprednisolone, micafungin, mycophenolate mofetil, tacrolimus, broad-spectrum antibiotics, as well as central hyperalimentation.
The Answer Is in the ERG
Paula Pecen, MD and Amy S. Babiuch, MD
A 29-year-old Iraqi male who moved to the United States in 2013 presents for evaluation. He complains of a 10-year history of floaters with recent onset of flashes in both eyes. He also notes a long history of nyctalopia and states that he was diagnosed with an eye disease in Baghdad when he was 15 years old. A review of systems is notable for intermittent headaches. Family history of eye disease or major medical problems is negative.
Best-corrected visual acuity (BCVA) measured 20/40 in the right eye and 20/30 in the left eye. Pupils were minimally reactive to light in both eyes, with no afferent pupillary defect (APD). Confrontation visual fields revealed peripheral constriction in both eyes. Intraocular pressure (IOP) and extraocular motility were within normal limits. Anterior segment examination was significant for mild posterior subcapsular cataract in both eyes.
Fundus examination was notable for vitreous condensation, especially at the vitreous base in both eyes. Both optic nerves had small cup-to-disc ratios with mild pallor. Retinal pigment epithelial (RPE) changes were noted in both maculas. The periphery of both eyes revealed arteriolar narrowing, pigment clumping, and chorioretinal atrophy.
OCT of the right and left macula demonstrated trace cystic retinal changes in both eyes. Fluorescein angiography (FA) exhibited normal arteriovenous transit times with no abnormal macular leakage. Electroretinogram (ERG) demonstrated significantly diminshed response to dim light in the dark-adapted state. Responses to bright light under both dark- and light-adapted conditions reveal similarly delayed and reduced waveforms by about 30-50%.
A Hereditary Anomaly
Vincent Y. Ho, MD; Enchun M. Liu, MD; and Richard J. Rothman, MD

A 48-year-old male was referred for evaluation of retinal vascular changes in his left eye. The patient had no visual complaints and denied any ocular or medical history. His family history consisted of unspecified cancer in his father and maternal grandmother, and a review of systems was positive for frequent epistaxis.
Visual acuity (VA) measured 20/20 in both eyes, there was no relative afferent pupillary defect, and intraocular pressure (IOP) was 18 in both eyes. Anterior segment exam was significant for mild vascular tortuosity of conjunctival vessels and mild cataracts in both eyes.
Dilated fundus exam revealed clear vitreous, sharp and pink optic nerves, mild macular RPE mottling, and normal periphery in both eyes. The vasculature was normal in the right eye but a telangiectatic, branching vascular anomaly concentrated along the papillomacular bundle was found in the left eye.
Fundus photography and a fluorescein angiogram (FA) were obtained. FA was normal in the right eye but revealed arterial filling of a peripapillary vascular malformation in the left eye without leakage.
Upon further questioning, the patient endorsed a family history of hemorrhagic telangiectasias.
A Numbing Case of Retinal Vasculitis With Multiple Differential Diagnoses
Ashvini K. Reddy, MD; Diba Osmanzada, BS; and Susan Osmanzada, BS

A 43-year-old Caucasian man is referred for evaluation of increased floaters and decreased vision in both eyes for 6 weeks. He is afebrile with no unusual rashes, enlargement of the lacrimal glands, or lymphadenopathy. Review of systems is remarkable for fatigue, frequent headaches, and generalized weakness. He has had intermittent numbness of his lower extremities for more than 10 years. Family history is remarkable for breast cancer, lung cancer, colon cancer, and skin cancer.
Best-corrected visual acuity (BCVA) is 20/25 in the right eye and 20/20 in the left eye. His pupil reaction is slightly sluggish in both eyes without an afferent pupillary defect (APD). Visual fields, intraocular pressure, and extraocular movement are within normal limits. Anterior segment examination is remarkable for quiet conjunctiva with a mixed population of keratic precipitates (fine and granulomatous) in both eyes. He has trace cell and 1+ cell in the anterior chamber of the right and left eyes, respectively. There is 2+ vitritis in both eyes.
Fundus photographs show hyperemic optic nerves with bilateral occlusive retinal phlebitis with scattered intraretinal hemorrhages. OCT of the macula demonstrates vitreous opacities without cystic retinal changes in both eyes. Fluorescein angiography (FA) demonstrates bilateral disc leakage with central and peripheral venous leakage with areas of peripheral nonperfusion.
Culture Shock
Vishak J. John, MD; Brent S. Betts, MD; and John C. Allen, BS

A 58-year-old woman was admitted to the intensive care unit for nonalcoholic steatohepatitis with cirrhosis, hepatoencephalopathy, and beta-hemolytic streptococcus bacteremia. On day 10 of hospitalization she complained of vision loss, eye pain, photophobia, and a 3-day headache. Her ocular history was significant for bilateral cataract surgery and vitrectomy in the right eye for vitreous hemorrhage secondary to proliferative diabetic retinopathy. These procedures were performed at an outside hospital more than 2 years prior to her current admission.
On examination her visual acuity (VA) at bedside was only hand motions, no relative afferent pupillary defect was present, and intraocular pressure (IOP) was 17 and 19 in the right and left eye, respectively. Her anterior segment examination was significant for a hazy anterior chamber in the right eye and 20% layered hyphema in the left.
Fundus examination of the right eye revealed a hazy vitreous with scattered microaneurysms around the macula and a 4 mm circular, creamy, yellow-white subretinal lesion 2 disc diameters temporal to the fovea. The left fundus was unable to be visualized. B-scan ultrasound of the left eye revealed a 7.27 mm x 1.56 mm retinal lesion.
What's your diagnosis?
Why an On-the-Dot Diagnosis Is Necessary
Zeina Haddad, MD, and Ashvini K. Reddy, MD

A 33-year-old highly myopic Caucasian woman presented with decreased vision and distortion in her left eye. Her history dated back 13 years when she had progressive painless decreased vision in the right eye, followed 3 years later by decreased vision in the left eye. Her family history was unremarkable.
She was initially diagnosed with bilateral multifocal choroiditis with panuveitis (MCP).
Immediately following diagnosis, she underwent multiple intravitreal and subtenon steroid injections and intravenous Solu-Medrol (methylprednisolone, Pfizer, Inc, New York, NY). Two years prior, she began systemic prednisone and mycophenolate mofetil, under which she was well controlled, but these were discontinued 1 year later. Over the past 6 months, she has been off all medications.
In addition to her reported decreased vision and distortion in the left eye, vision was 20/50 (stable for 10 years) in the right eye and 20/25 in the left eye (decreased from 20/20). Her visual fields were full to confrontation. Her pupils were equally round and reactive to light with no afferent pupillary defect. External exam and extraocular motility were normal. Intraocular pressures were 14 and 19. Slit-lamp examination was remarkable for stable steroid-related posterior subcapsular cataract superior to the visual axis in the left eye. Her examination was specifically negative for anterior chamber cells, flare, vitreous cells, and vitreous haze.
What's your diagnosis?
What a Baseline Examination Uncovered in a Systemic Lupus Erythematosus Patient
Ashvini K. Reddy, MD, and Rabia Aman, BS

A 28-year-old African American female with systemic lupus erythematosus (SLE) and autoimmune lymphoproliferative syndrome is referred to the eye clinic by her rheumatologist for a baseline hydroxychloroquine (HCQ) eye examination 3 months after starting HCQ. The patient reports no vision changes since starting HCQ, but states she has always seen better out of her right eye. Best-corrected visual acuity (BCVA) is 20/20 OD and 20/25 OS with normal pupil reactions, extraocular motility, and intraocular pressure (IOP).
As part of her baseline HCQ screening, 10-2 Humphrey visual field testing is performed. Dilated fundoscopic examination is normal OD, but vascular changes and atrophy OS are noted. Optical coherence tomography (OCT) and fluorescein angiography (FA) are also performed.
What did the examination reveal?
I Survived Cancer, Now I Can’t See!
Bozho Todorich, MD, PhD; Prithvi Mruthyunjaya, MD; and Paul Hahn, MD, PhD

A 77-year-old woman complained of a symptomatic paracentral scotoma after uncomplicated cataract surgery in her left eye. She described the scotoma as a “thick grey streak” in her left inferotemporal visual field. The patient demonstrated constricted peripheral visual fields in both eyes and was initially referred to a glaucoma specialist, who did not note any evidence of glaucoma and subsequently referred her to the Duke Eye Center Retina Service for further evaluation.
Her medical history was significant for stage II non-small cell lung cancer (NSCLC), for which she underwent right upper-lobe resection 7 years prior. She maintained ongoing oncologic surveillance with no evidence of recurrence.
On examination, her visual acuity (VA) was 20/20 in the right eye and 20/25 in the left eye, with a left afferent pupillary defect (APD). Anterior segment examination was normal. On dilated fundus examination, optic nerves were normal, but she had trace epiretinal membrane (ERM) with mildly attenuated retinal vessels bilaterally and a few scattered hyperpigmented retinal pigment epithelium (RPE) changes in the midperiphery of both eyes (not captured with fundus photography).
Fundus autofluorescence (FAF) imaging showed normal perifoveal autofluorescence with a surrounding ring of abnormal hyperautofluorescence and patchy hypoautofluorescence in the midperiphery of both eyes corresponding to RPE changes observed on fundoscopic examination.
Spectral-domain OCT (SD-OCT) demonstrated a mild ERM with subtle distortion of the foveal contour. There was central preservation of the outer retinal layers, including the ellipsoid zone, but diffuse perimacular outer retinal thinning was apparent, worse in the left eye.
Humphrey visual field (HVF) (Carl Zeiss Meditec, Inc, Dublin, CA) testing showed peripheral visual field constriction bilaterally, which was more advanced in the left eye. Multifocal electroretinography (ERG) imaging showed near-extinguished macular ERG responses in both eyes.
Injection Infection
Ashvini K. Reddy, MD, and Thomas A. Mendel, PhD

A 24-year-old Caucasian man was referred to the retina clinic for evaluation of toxoplasmosis in the right eye following initial presentation at an outside eye clinic. He reported a 10-day history of pain and 1 day of eye redness. The patient was started on PO Bactrim (sulfamethoxazole/trimethoprim, AR Scientific, Philadelphia, PA) 1 week prior to referral with no improvement in pain and worsening vision.
On examination, the patient had hand-motion vision in the right eye, and the fellow eye was 20/20. He reported recreational intravenous (IV) drug use for 1 month, most recently the week prior to referral. The patient specifically denied any chronic medical problems and symptoms of infection, including fever, nausea, and chills. He had no prosthetic devices and tested negative for human immunodeficiency virus (HIV) in 2001.
Clinical examination revealed the patient was atraumatic with no lymphadenopathy. Fundoscopic exam was significant for diffuse vitritis with multiple fluffy infiltrates along strands of vitreous in the right eye. Focal vitritis, chorioretinal lesions, and a “headlight in a fog” appearance were notably absent. Examination of the left eye was normal.
A Case of White Chorioretinal Lesions Following Retinal Detachment Surgery
Heena R. Patel, MD, and Thomas A. Albini, MD, ASRS Website Committee Chair

A 52-year-old man presented with decreased vision in the left eye for 2 days. His medical history was significant for insulin-dependent diabetes mellitus and dialysis treatment, hypertension, and hyperlipidemia. His ocular history was significant for 3 retinal detachment surgical procedures in the right eye. Family history was significant for diabetes mellitus in his father.
On examination, his visual acuity (VA) was no light perception in the right eye and 20/25 in the left eye. Anterior segment exam showed a surgical pupil with neovascularization of the iris in the right eye and 1+ cell in the anterior chamber of the left eye. Fundoscopic view of the right eye was hazy with hemorrhages obscuring the view of the posterior pole. The left eye had 1+ vitreous cell and multiple, deep chorioretinal lesions throughout the posterior pole and peripheral fundus. Subretinal fluid was present anterior to the equator inferiorly.
Pigmentation Isn't Just Skin Deep
Ashvini K. Reddy, MD, and Matthew Doerr, MD, MS

A 25-year-old Caucasian woman was referred for evaluation of chronically decreased visual acuity (VA) in both eyes. She denied any previous medical or ophthalmologic history and stated her vision had never been good, even with glasses or contact lenses. She denied any history of trauma or unusual exposures.
Best-corrected VA (BCVA) is 20/25 OU, and external examination is within normal limits. She has blonde hair and fair skin. Extraocular motility is normal, and the patient is orthotropic without nystagmus.
Slit-lamp examination is significant for pale blue irides with diffuse transillumination defects. There is no intraocular inflammation, and the lens is clear in each eye. Fundus examination is remarkable for pink optic discs and the absence of a foveal light reflex in both eyes with a "blonde" fundus. OCT demonstrates an abnormal foveal contour.
What's your diagnosis?
It's Not Just a Macular Scar
Ronakorn Panjaphongse, MD, and Jay M. Stewart, MD

A 58-year-old Asian man was referred for vitreoretinal consultation. He had recently visited an ophthalmologist for a comprehensive exam, complaining of blurred vision in both eyes that had gradually worsened over the past 2 years. He had no history of ocular injury, radiation treatment to the head, or other systemic diseases, but he had smoked for at least the past 10 years. No one in his family had similar vision problems.
His vision was 20/80 in the right eye and 20/60 in the left eye, with normal intraocular pressure (IOP). He had mild nuclear sclerosis cataract in both eyes, and anterior-segment examination in each eye was otherwise unremarkable.
What's your diagnosis?
Why a Genetic Test Is Sometimes Worth a Shot
Ashvini K. Reddy, MD, and Thomas A. Mendel

A 45-year-old Caucasian man reported decreased vision for 3 years with insidious onset. The patient had no history of rheumatic joint disease, sarcoidosis, or other inflammatory disorders and had a negative purified protein derivative (PPD) 2 years prior. His best-corrected visual acuity (BCVA) was 20/40 OU.
Examination was remarkable for the absence of lacrimal enlargement or granulomas. He had no keratic precipitates (KP), posterior synechiae, or anterior-chamber cell or flare, and there was bilateral 2+ vitritis.
Fundus examination was remarkable for pale, ovoid lesions most prominent nasal to the optic disc. There was mild retinal vasculitis and an epiretinal membrane. Mild increased retinal thickness was evident on OCT. Fluorescein angiography (FA) and indocyanine green (ICG) angiography were performed, and demonstrated hypofluorescent areas.
The Case of the Woman With Blurry Vision for 1 Year and Difficulty With Low-Contrast Targets
Shlomit Schaal, MD, PhD, and Douglas Sigford, MD

A 57-year-old Caucasian woman presented with a complaint of blurry vision in both eyes for 1 year. She also noted more difficulty with low-contrast targets as well as photopsias OU; onset was insidious. Her medical history was significant for hypothyroidism of unknown etiology, for which she was taking levothyroxine, and for mitral valve prolapse. She noted submandibular lymphadenopathy around the time her symptoms began. She had no ocular history, and her family history was significant only for macular degeneration in a maternal grandfather.
Best-corrected visual acuity (BCVA) measured 20/30-2 OD (-1.25+1.50x180) and 20/50+2 OS (-0.25 sphere). Pupils, extraocular movements, gross confrontational visual fields, and intraocular pressures were normal. Her anterior segment was unremarkable, and she had no vitritis OU. Dilated fundoscopy revealed small (<50 µm), deep, yellow/white lesions in the central macula OU. There was no retinitis, vasculitis, or papillitis, and the peripheral retina was unremarkable.
OCT showed a diffuse, granular disruption of the ellipsoid region of the photoreceptor outer segments OU. This was more prominent subfoveally, where there was a loss of distinction between the external limiting membrane (ELM) and the ellipsoid region. Fundus autofluorescence (FAF) also showed a granular pattern of disruption.
Which Came First, the Diagnosis or the Egg?
Ashvini K. Reddy, MD; Steven A. Newman, MD; and Alexander Y. Kim

A 27-year-old male was referred for evaluation of decreased central acuity. His ophthalmic history was significant for hyperopic astigmatism, bilateral macular pigmentary changes, and a relative central scotoma. According to the patient, all had been present since childhood.
His records indicated that his visual acuity (VA) was 20/25+1 in both eyes in his teenage years. He stated that vision in both eyes had gradually worsened and reported no other problems.
Family history was notable for glaucoma in his maternal grandfather, macular degeneration in his maternal grandmother and great uncles, diabetes in his maternal and paternal grandfathers, and atherosclerotic cardiovascular disease in his paternal grandfather.
On examination, his best-corrected VA (BCVA) was 20/40 in both eyes. Visual fields were full to confrontation, but 10-2 automated visual fields were significant for symmetric bilateral central scotomas. An Amsler grid test was normal. Pupillary response and extraocular motility were normal, and color vision testing with Hardy-Rand-Rittler pseudoisochromatic plates was normal in both eyes.
Far-East Movement
Steven Yeh, MD; John D. Kim, MD, FACP; Brandon B. Johnson, MD; and Purnima S. Patel, MD

A 57-year-old Korean male diabetes patient with a history of cholangitis and choledocholithiasis underwent endoscopic retrograde cholangiopancreatography (ERCP) with biliary stenting 2 months prior to presentation. One month following the initial procedure, persistence of a common bile duct stone prompted repeat ERCP with biliary stent repositioning.
Over the ensuing week, the patient developed abdominal pain, fever, and chills. He also complained of a 24-hour history of vision loss, pain, and redness in the right eye.
The patient was referred to the Emory University Hospital emergency department, where he also received an ophthalmology consultation.
Visual acuity was counting fingers at 3 feet in the right eye and 20/20 in the left eye. A relative afferent pupillary defect was observed in the right eye. Slit-lamp examination showed 4+ anterior chamber cell and a 1 mm hypopyon in the right eye. Fundoscopic examination showed 2+ vitreous haze and a yellow subretinal lesion with overlying hemorrhage involving the temporal macula (Figure 1). The left eye was normal.
Not Your Average Eye Infection
Phoebe Lin, MD, PhD, and Neal V. Palejwala, MD

A 52-year-old immunocompetent male with moderate developmental delay presented with a 10-day history of red eye, photophobia, and decreased vision in the left eye. Per his caregiver, he had a history of viral encephalitis nearly 10 years ago. At that time, a herpes simplex virus (HSV) polymerase chain reaction (PCR) cerebrospinal fluid (CSF) test came back negative. There was no history of maternally transmitted infection or other infectious or pertinent medical history. The patient denied any occurrence of ocular disease, injury, or surgery.
Upon examination, visual acuity was 20/30 in the right eye and hand motions vision in the left eye. An afferent pupillary defect was present in the left eye, and intraocular pressure (IOP) in both eyes was within normal limits.
Do I Have Cancer?
Royce W.S. Chen, MD; J. William Harbour, MD; and Audina M. Berrocal, MD, FACS

A 20-year-old woman from Honduras presented with decreased vision in the left eye over the past 2 months. She reported transient episodes of complete bilateral visual blackout, as well as intermittent headaches for 12 months prior to examination. She also stated that she had fainted 3 times in the week prior to examination.
Her medical history was significant for mild sensorineural hearing loss, for which she was evaluated 3 years prior. Studies at the time were inconclusive. Family history was significant for a maternal uncle with liver cancer and a maternal grandmother with breast cancer.
The patient nervously asked, “Do I have cancer?”
What's your diagnosis?
A Unique Case of Unilateral Acute Idiopathic Maculopathy
Oscar Kuruvilla, MD; Shareef Ahmed, MD; Nitin Kumar, MD; and Uday R. Desai, MD

A 35-year-old male presented to the retina clinic after sudden loss of vision OS. Other than this presenting complaint, he was asymptomatic, including no report of flashes, floaters, or pain. He denied any recent illnesses, and ocular history was significant only for LASIK surgery approximately 11 years prior to presentation.
Significant medical history included sleep apnea and allergic rhinitis, which was not being treated with nasal steroids. Family history included AMD and glaucoma in first-degree relatives.
What's your diagnosis?
Years Later, You're Still the Same
Christopher R. Henry, MD; Harry W. Flynn Jr, MD; and Thomas A. Albini, MD, ASRS Website Committee

A 63-year-old female presents for a scheduled follow-up examination. She reports being blind OD for over 40 years and having stable vision OS. She denies any significant medical history, including no history of diabetes mellitus or hypertension. Ocular family history is significant for a son with a retinal disorder.
Explaining the Exudates in a 15-Year-Old Healthy Female
Christina Y. Weng, MD, MBA, and Janet L. Davis, MD

A 15-year-old healthy Caucasian female presented with a 6-week history of decreased vision and floaters OS; she denied flashes, pain, or metamorphopsia. Patient had received Gardasil and varicella booster vaccinations 3 months prior. Additionally, she had recently been treated with oral cephalexin for a skin infection from a domesticated dog bite.
Born full-term, the patient was healthy, on no medications, and had an unremarkable review of systems. Her ophthalmologic examination was normal 4 years ago. Her mother had childhood strabismus, but no significant visual deficit. Patient denied substance use, lived with no pets, and had not travelled recently.
Why a High Index of Suspicion and Prompt Diagnosis are Critical
Keyvan Koushan, MD, FRCSC, and Shailesh K. Gupta, MD, MBA

A 23-year-old black female presented with a 2-day history of sudden-onset redness, photophobia, pain, and tearing OS. She had been placed on gentamicin drops by her primary care physician with no improvement of her symptoms. Ocular history was unremarkable and medical history was significant for mild hypertension and mild developmental delay. Social history was significant for having multiple sexual partners in the past 2 years and being repeatedly tested for HIV in the past (all being negative).
Examination revealed best corrected visual acuity of 20/20 OD and 20/30+2 OS. Pupils were equally reactive with no afferent pupillary defect. Slit-lamp examination was unremarkable OD, and significant for diffuse conjunctival injection and 4+ cells and flare OS. There were no keratic precipitates. Early formation of posterior synechiae was evident OS.